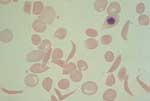
Νέα στοιχεία για τη δρεπανοκυτταρική αναιμία

Νέα στοιχεία για τη δρεπανοκυτταρική αναιμία
Λονδίνο: Την αιτία που η δρεπανοκυτταρική αναιμία "προτιμά" κυρίως τους άνδρες και όχι τις γυναίκες ανακάλυψαν Αμερικανοί ερευνητές, σύμφωνα με άρθρο που δημοσιεύεται στο επιστημονικό έντυπο Circulation: Journal of the American Heart Association.

Αριθμός Πιστοποίησης Μ.Η.Τ.232442
Αριθμός Πιστοποίησης Μ.Η.Τ.232442